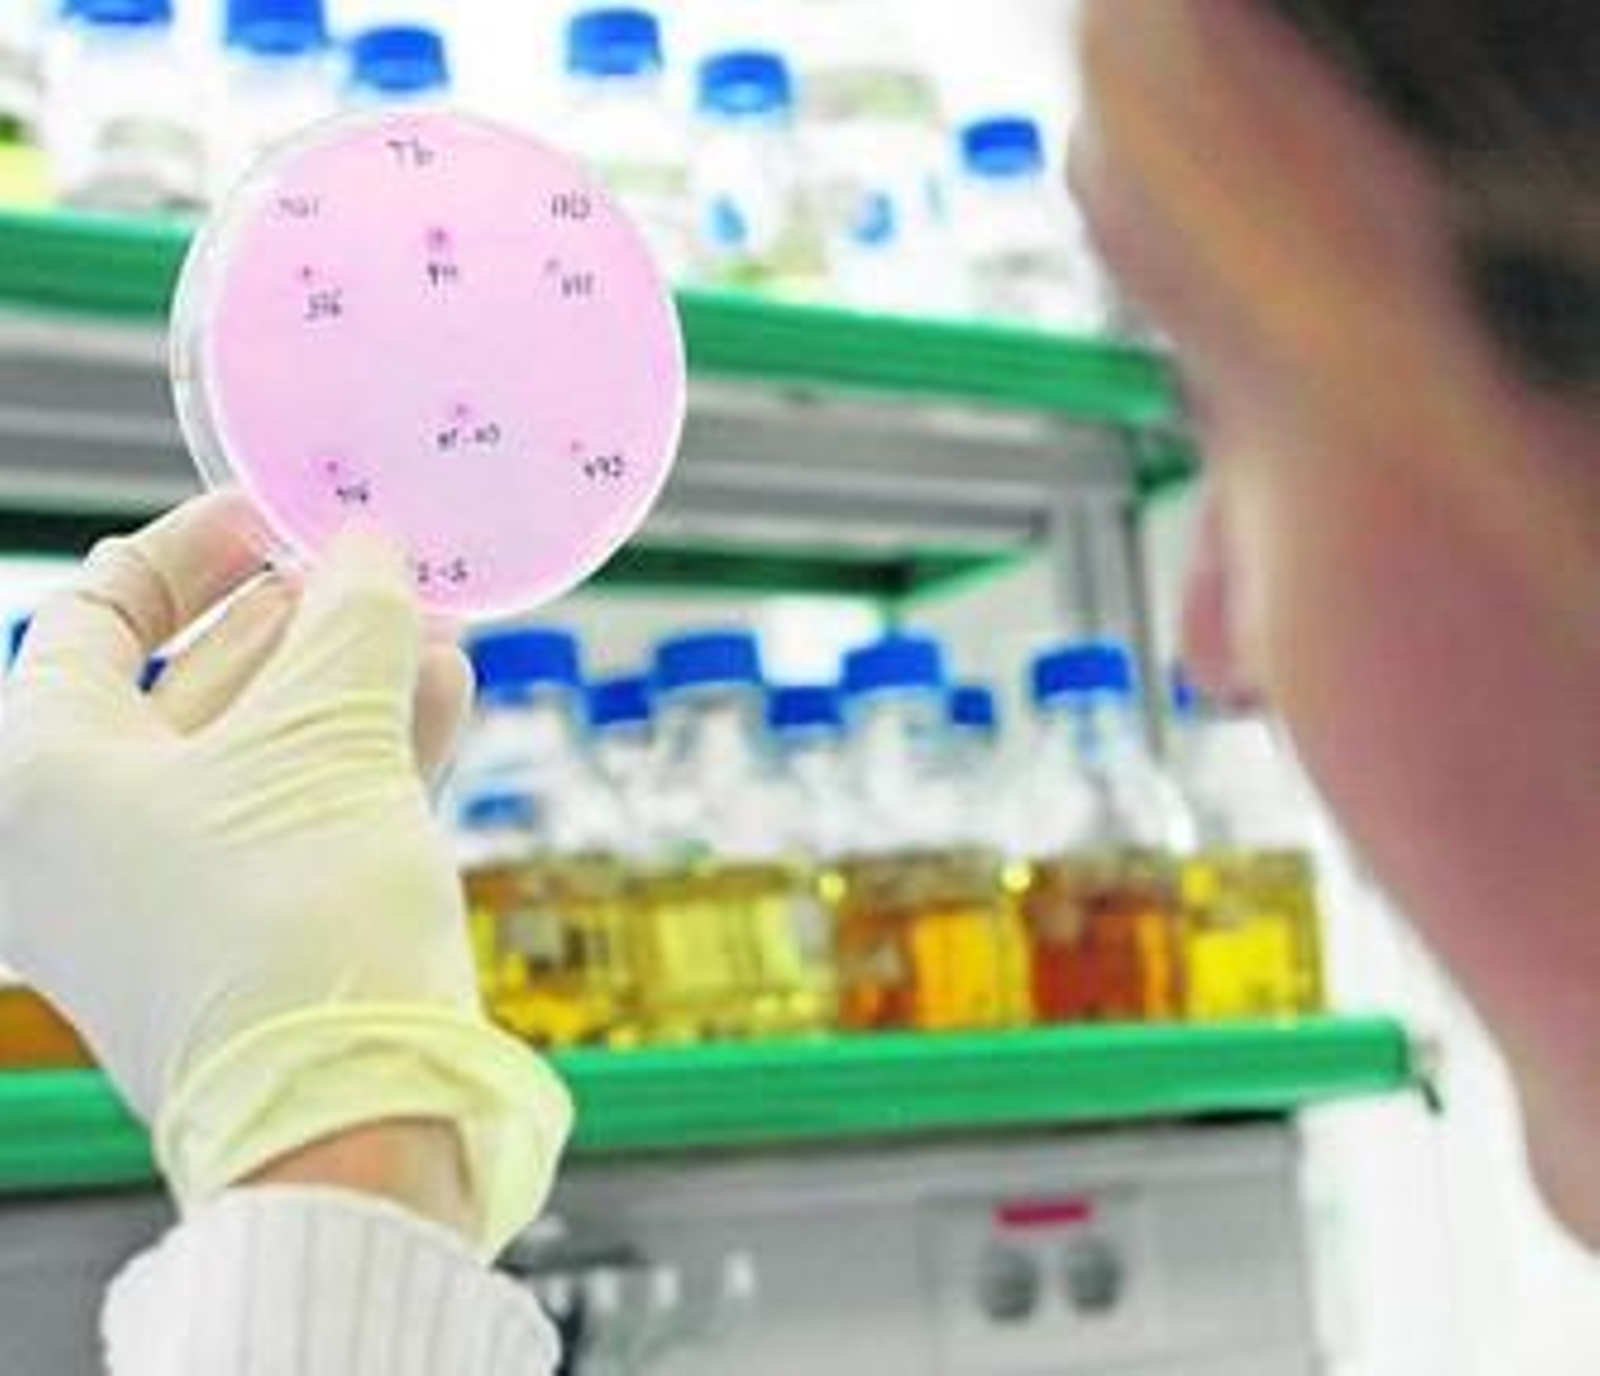
El objetivo es desarrollar moléculas hasta su ensayo en pacientes.

Neuron Bio patenta dos compuestos que evitan la muerte de las neuronas
Sus características permiten que se usen como tratamiento para retrasar el Alzheimer

La empresa granadina Neuron Bio ha patentado dos compuestos que protegen de la muerte de las neuronas y que penetran con alta eficiencia en el cerebro, dos características fundamentales para ser usadas como tratamientos que retrasen el inicio de la enfermedad de Alzheimer y de otras enfermedades neurodegenerativas.
Los compuestos, codificados como NST0076 y NST0078, han sido desarrollados gracias a los conocimientos acumulados por los investigadores de la compañía tras evaluar miles de potenciales candidatos. Para la selección de estas moléculas se ha utilizado la plataforma exclusiva de descubrimiento que posee la compañía, y que integra modelos de esta enfermedad en células humanas y en modelos animales.
La patente que protege estos dos nuevos compuestos pasa a aumentar la cartera de moléculas patentadas por Neuron Bio, incrementando el valor de la compañía. El modelo de negocio de Neuron Bio es desarrollar las moléculas hasta su ensayo en pacientes (fase 2) momento en el que alcanzan su mayor atractivo para la venta de la tecnología a empresas farmacéuticas que realizarán las fases posteriores y la comercialización de los fármacos.
También te puede interesar
Contenido ofrecido por el Colegio de Veterinarios de Granada
Contenido ofrecido por Aguasvira
Contenido ofrecido por CEU en Andalucía











